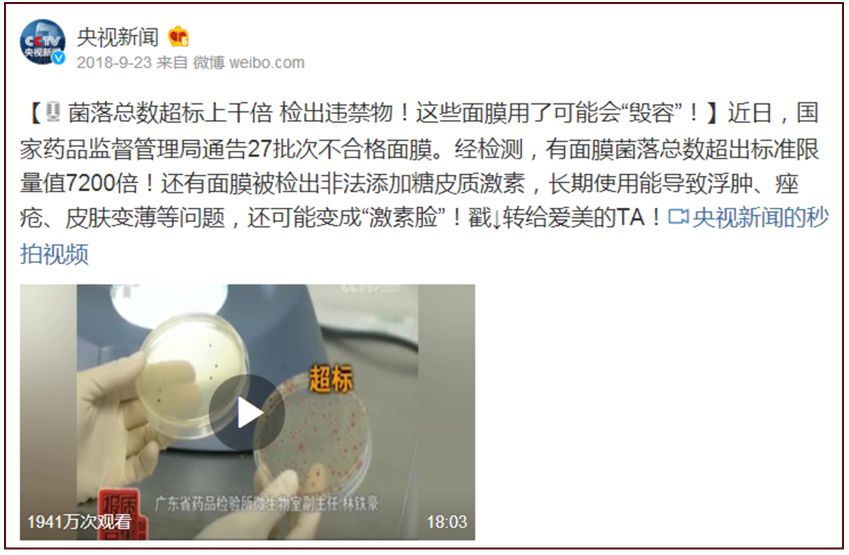
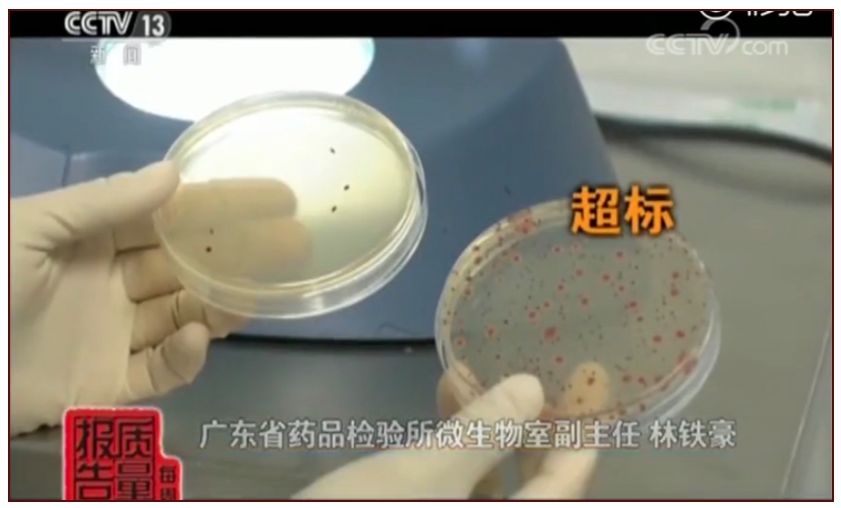

央视曝光27批次不合格面膜,超标7200倍,用完就烂脸!!
天气热了
仙女们护肤必不可少的就是面膜了
可是哦 面膜真的不能乱用
最近哦 央视曝光27批次不合格面膜
超标7200倍,用完就烂脸!!
可真的吓死我了
我的好朋友拖拖最近写了这篇文章
我赶快分享给你们看看

中国已经成为人均使用面膜第一的国家
面膜,最好骗钱了
所以你会发现面膜的种类越来越多
面膜的功效也越来越多
甚至身边卖面膜的人也越来越多
今天就不讲微商了
我们来讲讲更无良的厂商
有人做坏事,当然就有人治
去年9月,央视新闻就曝光了一大批不合格面膜
指出很多不合格面膜的菌落总数超出
标准限量值的7200倍
你以为你敷的是面膜,是营养
殊不知,细菌早就爬满了你整张脸
想想都可怕
事情源于国家药监局去年公布的
27批次不合格面膜通告
(百度搜索关于27批次查看详情)
加上网上很多面膜过敏的视频被热播
严重的,整个面部都发生红肿
眼睛都睁不开
于是,有心的记者就开启了
探索真相的道路
(我也想转行当个记者了)
第一家
广州博羿化妆品有限公司
淘宝:茜茜雨露旗舰店
在网上看到有人说用了它家面膜之后
长粉刺和红血丝
于是,记者就去问客服是怎么回事
一开始客服会说
有可能是因为客户自己是敏感皮
可不能怪产品
毕竟现在敏感皮,对啥都敏感
然后说因为产品里面都是植物提取物
这类成分比较容易引起过敏
说得没有错哦,天然植物成分
可是更容易引起过敏的
然后记者带着去权威机构检测
面膜菌落超标84倍
我们的皮肤是有自己的菌群的
菌落过多会打破我们的菌群
导致菌落失调
然后影响我们的皮肤屏障和自然酸碱度
皮肤有损伤,菌落还会趁机进入
如果含有细菌,还会引起感染
它们家还有3款面膜菌落都超标
最低都有20倍
分别是
茜茜雨露洋甘菊舒缓调理面膜
茜茜雨露熊果苷雪颜亮肤隐形面膜
茜茜雨露备长炭净颜水润黑金面膜
最可怕的是什么
你们知道吗?
是,这份报告是去年6月份
央视公布也是去年9月份
而今天,2019年5月22日
这些面膜淘宝旗舰店仍然有售
我查了一下,27个批次
除了上面这家店这么大胆之外
在淘宝上还能找的还有
比比兔®备长炭清爽保湿面膜
海洋传说深海鱼油高倍水润面膜
城市物语®竹炭纤维保湿紧致面膜
名蔻玻尿酸水漾透亮双层面膜
若泉水磁场立润保湿蚕丝面膜
水盈七子白水分缘面膜
谷幽兰维生素E-B嫩肤补水面膜
谷幽兰净白面膜
玉颜面膜一号和玉颜面膜二号
台湾森田保湿精华水嫩面膜(上海公司代理)
想要获取完整的不合格面膜名单
关注拖拖的公众号
/野生皮卡拖/
回复“不合格面膜”就可以获取啦
在「野生皮卡拖」这里
你可以看到很多很接地气的分享
都是很实用的美妆|护肤|穿搭的知识



(友情提示:直接点击你想知道内容就可以查看哦)
还有更多的精彩内容
关注后点击往期文章就能看到啦
做她的粉丝真的是炒鸡幸福
不仅能跟着她变美
还能获得小礼物哦 超级宠粉哒
还等什么,赶紧关注吧等你来撩哦~
以上内容为精读君的友情互推,推荐文案由对方提供,请大家独立思考,根据自己的喜好选择适合的公众号。谢谢大家的理解。